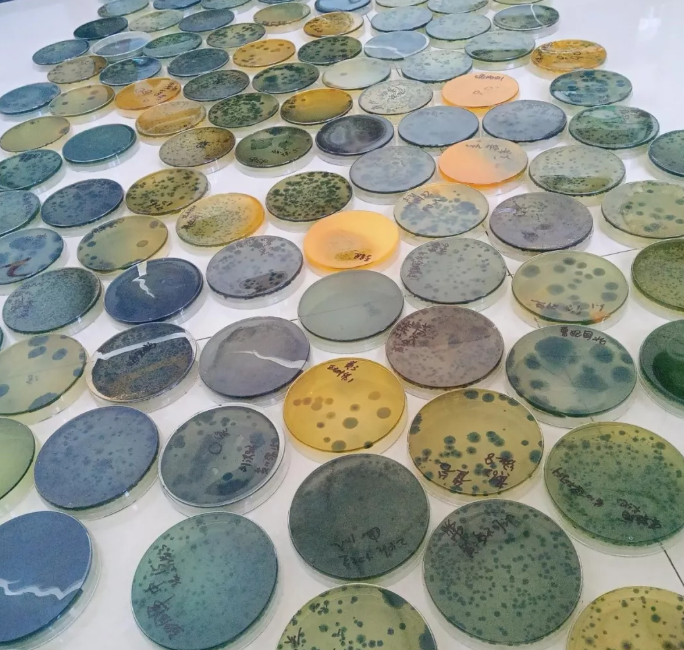

弧菌=对虾的绝症?作为对虾养殖的头号杀手,可以引起早期的肝胰腺坏死,空肠空胃,偷死等各种绝症。虾子一旦染上弧菌就非常棘手了!大家对付弧菌的方法一般就是用各种杀菌消毒药,最近两年流行50%的过硫酸氢钾复合盐。但是,除了消毒杀菌我们就没有更好的办法了吗?作为底栖动物,对虾得弧菌病主要由池底弧菌大量爆发、池底环境恶化以及对虾体质差共同导致的。池底环境恶化是池底弧菌会大量爆发以及对虾体质会变差的根本原因。本文将揭秘池底环境对弧菌爆发以及体质变差的影响。

一、为什么池底的弧菌会爆发
为什么池底的弧菌更多?主要因为池底环境更能够满足弧菌的快速生长。特别是底部溶氧低,弧菌会随着温度的升高快速繁殖!

1.1池底弧菌数量是中上层水的几十倍

养殖户平时检测的都是上层水样的弧菌,将其认为是整个池塘的弧菌含量,殊不知,上层水样常常是弧菌含量最少之处,底层弧菌和上层弧菌含量差别大,如图显示,上下层的弧菌明显不是一个数量级的,如果简单的检测上层pH,极易造成判断严重失误。
1.2池底有机质占池塘有机质总量可达80%
弧菌弧菌生存就需要附着在有机质上,养殖中后期投饵量的加大,造成底部残饵粪便越来越多,创造了弧菌适合生长的环境,弧菌就会大量的繁殖。养殖中后期,池底淤泥中的有机质占整个池塘有机质可达80%,因此,池底弧菌更多的原因之一就是池底的有机质多,营养充足。
2.3池底氧债高
芽孢杆菌等有益菌在溶氧充足的环境中才能顺利生长,但弧菌都喜欢生长在厌氧的环境中,我们在养殖过程中池塘上层水体溶氧往往是足够的,而池塘底部往往是厌氧的环境,弧菌在缺氧的条件下繁殖很快。因此池底会有大量弧菌生成。对虾又是在池底活动,池底缺氧也会造成对虾体质变差,更易受到弧菌感染发病。
2.4池底pH低
芽孢杆菌等有益菌在微碱性的环境中才能顺利生长,但弧菌在酸性环境下也能够快速生长繁殖,池塘底部往往是pH偏低的环境,弧菌在pH偏低的池底繁殖很快。因此池底有益菌难以生长繁殖,会有大量弧菌生长繁殖,这也就是为什么池底弧菌更多的原因之一。
池底弧菌过多的原因主要是池底有机质过多,氧债高,pH低,因此如何将池底的有机质减少,降低氧债以及提高pH至关重要
二、对虾体质变差也是池底环境恶化引起的
对虾作为底栖动物,如果池底环境恶化,比如溶氧偏低,“一天缺氧三天不长”,会影响对虾正常摄食和脱壳,长期缺氧就会导致对虾体质变差;池底pH过低,影响鳃等器官对水体营养物质的利用,也会增加硫化氢的毒性,导致对虾中毒,体质变差。因此,如何确保对虾良好的体质,保持池底有足够的溶氧以及适合的pH至关重要。
三、如何减少池底弧菌病的爆发
池底环境的恶化是弧菌大量的爆发和对虾体质变差的根本原因,因此保持良好的池底环境至关重要,如何保持良好的额池底环境呢?
3.1提高池底pH
把块状的生石灰加工成鸡蛋大小,向池塘均匀干撒,沉入池塘底部,用量根据酸化呈度,30-40斤/亩不等。使用生石灰不仅可以提高水体的pH,也能够向水体中补充大量的钙。维持池底pH在7.5-8.5,不仅能够减少弧菌的大爆发,也可以维持对虾良好的体质。
3.2提高池底溶氧
首先,使用增氧设备,加大水体的搅动,将上层高溶氧水搅动到池底,增加池底的溶氧;其次,可以通过定期使用增氧颗粒,增加池塘底部的溶氧;通过换水,补充高溶氧的水源,提高池塘的溶氧。保持池底充足溶氧,弧菌难以生长,对虾体质也会良好。
3.3减少池底有机质
如果有排污口,可以加大排污水的量和频次,减少池塘有机质的积累;其次,池底有机质过多,可以通过强氧化剂氧化清除掉池底的有机质,减少池底有机质的聚集。
四、小结
弧菌大量的爆发和对虾体质变差的根本原因是池底环境的恶化,尤其是池底溶氧不足和pH过低。但在养殖过程中,养殖户平时检测的都是中上层溶氧和pH,将其认为是整个池塘的溶氧和pH,殊不知,此时,池底已经缺氧和酸化,对虾体质已经变差,弧菌也会大量爆发,此时处理就晚了一步。